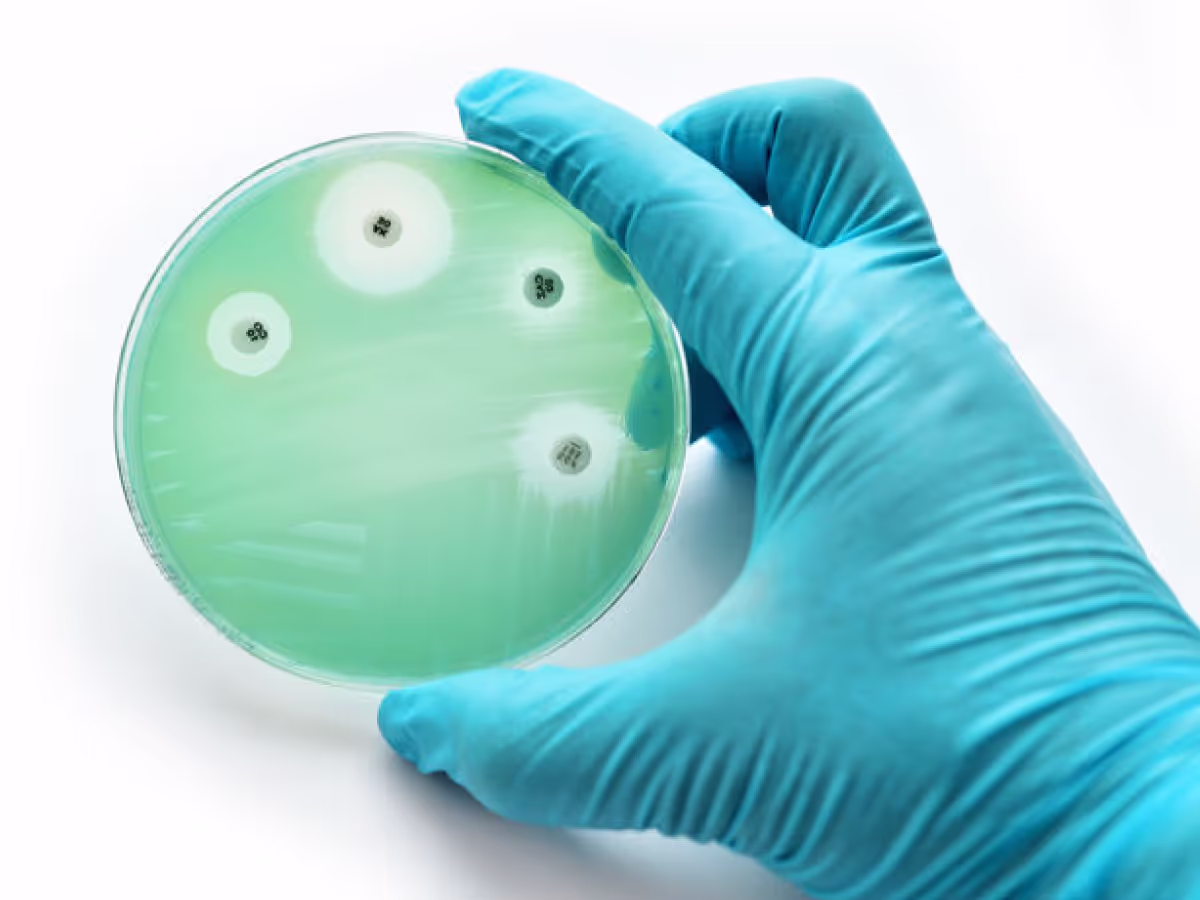

Für einen optimalen Ablauf Ihrer Operation
Unsere OP-Raumlufttechnik sorgt dafür, dass Patienten sicher und zufrieden zu ihren Familien zurückkehren können.
Denn der Erfolg Ihrer OP und die Zufriedenheit Ihrer Patienten stehen für uns an erster Stelle.
Gemeinsam verfolgen wir das Ziel, Ihren Patienten zu helfen und zur Genesung beizutragen.
Lassen Sie uns beginnen, indem wir potenzielle Gefahrenquellen in Ihrem OP-Saal identifizieren und eliminieren.

Einblicke in die tödliche Gefahren eines Schlecht belüfteten OP
Traurige Fakten über nosokomiale Infektionen
Todesfälle durch Infektionen im OP
Wundinfektionen Ursach
Mikrobiologische Besiedlung
Häufigste Infektionen

Anteil der bei Wundinfektionen gewonnenen Isolate (%) nach Fachgebiet
Schockierende Folgen
-
Verlängerung des Krankenhausaufenthalts – bis zu 14 Tage
-
Erhöhung des Sterberisikos
-
Kosten in Deutschland: ca. 1,5 Milliarden €/Jahr
Studie Beweist
Ein schlecht geplantes Lüftungssystem kann sehr gefährlich werden

Untersuchungsbereiche der Studie
Die Instrumente im 1b-OP sind fünfmal stärker mit Keimen belastet als Instrumente unterhalb einer TAV-Decke!
Erkenntnisse
Gefährliche Keime in der Luft – Eine unsichtbare Bedrohung
Diese Erkenntnis zeigt deutlich, wie wichtig die Wahl des richtigen Lüftungssystems ist
Entscheidend ist das Zusammenspiel aller Komponenten. Nur so können wir eine sterile und sichere Umgebung im OP gewährleisten und das Risiko minimieren.
VITA BREVIS, "ARS" LONGA
Durch Spezialisierung neue Innovationen schaffen
Keimfreie Luft in Ihrem OP
Schützen Sie sich und Ihr Personal
Erstaunlich geringer Platzbedarf
Immer optimale Luftreinheit
Neuester Stand der Technik
OP-Raumlufttechnik begeistert Ärzte
Klimatechnik Made in Germany
Einzigartige Patentlösungen
Premium-Wartungen
Alles aus einer Hand
100% OP-spezialisiert

Werden Sie allen Anforderungen gerecht!

Sie erhalten OP-Raumlufttechnik gebaut nach deutscher NORM und Regelweken:
- VDI 6022
- VDI 2083/3
- DIN 1946-4
- DIN EN ISO 14644

Sie erhalten OP-Raumlufttechnik gebaut nach deutscher NORM und Regelweken:
- Hygieneverordnung
- OP Bauvorschriften
- Medizinproduktegesetz
- Betreiberverordnung

Sie erhalten OP-Raumlufttechnik gebaut nach deutscher NORM und Regelweken:
- Strömungsrichtung
- Luftgeschwindigkeit
- Temperatur
- Dokumentation

Garantierte Sicherheit mit der neuesten OP-Raumlufttechnik von Rentschler-Air
Technische Abnahme garantiert
Rentschler-Air garantiert Ihnen die technische Abnahme bei der Inbetriebsetzung sowie die periodische Überwachung Ihrer OP-Raumlufttechnik.
Voraussetzung für die Abnahme ist der bestandene Filterdichtheitstest „Lecktest“ nach VDI 2083/3 (Messtechnik in der Reinraumtechnik) sowie der Nachweis der Regelungsstabilität der Anlage, der sowohl im Nennlastfall als auch im Stützbetrieb vorzunehmen ist. Filterdichtheitstests und Lecktests werden mindestens alle zwei Jahre oder nach Eingriffen an der Endfilterstufe wiederholt.
Im Rahmen der strömungstechnischen Überprüfung wird mithilfe von Partikelmessungen innerhalb und außerhalb des Schutzbereichs der OP-Zuluftdecke der erreichte Schutzbereich festgestellt. Die Abnahme erfolgt unter der Begleitung und Beurteilung eines zuständigen Krankenhaushygienikers.
Bei der Geräuschmessung darf der Schalldruckpegel bei voller Leistung mit produktspezifischem Nennluftstrom im Feldmittel auf einer Höhe von 1,75 m ü. FB den Wert von 48 dB(A) nicht überschreiten. Über dem Anästhesie-Arbeitsplatz ist ein Wert von 45 dB(A) einzuhalten.
Hygienische Abnahme garantiert
Rentschler-Air garantiert Ihnen die hygienische Abnahme bei der Inbetriebsetzung sowie die regelmäßige Überwachung Ihrer Raumlufttechnik.
Die Voraussetzung für die hygienische Abnahme ist die bestandene technische Abnahme sowie eine gründliche Reinigung. Die Abnahme umfasst eine Begehung der RLT-Anlagen und der von diesen versorgten Räume sowie eine hygienische Untersuchung der RLT-Anlagen in allen relevanten Bereichen.
Die periodische Überprüfung der Strömungsverhältnisse entlang der Randzone erfolgt mittels Strömungsprüfröhrchen mindestens vierteljährlich während des OP-Betriebs (unter Berücksichtigung der natürlichen Wärmelasten). Diese wird vom zuständigen Krankenhaushygieniker stichprobenweise begleitet und beurteilt. Dies fördert sowohl den Kontroll- als auch den Lerneffekt für das reinraumgerechte Arbeiten des OP-Personals.
Über die Notwendigkeit von mikrobiologisch-hygienischen Kontrollen nach der technischen Abnahme und während des laufenden Betriebs entscheidet der zuständige Krankenhaushygieniker.
Rentschler-Air Warneinrichtung mit Echtzeitüberwachung
Sofortmaßnahmen bei Ausfall oder Störung Ihrer RLT-Anlage.
Ein Ausfall oder eine Störung der Anlage wird durch eine selbsttätige Warneinrichtung angezeigt, die mit integrierten Warnleuchten ausgestattet ist. Maßnahmen, die die Beschäftigten und sonstigen anwesenden Personen betreffen, werden sofort zur Kenntnis gegeben.
Regelmäßige Wartungen Ihrer RLT-Anlagen garantiert
Entsprechend § 4 Abs. 3 ArbStättV werden die RLT-Anlagen von Rentschler-Air gemäß den im Absatz 1 festgelegten Intervallen fachgerecht gewartet.
Ihre Wartungsintervalle werden so definiert, dass die technischen, hygienischen und raumlufttechnischen Eigenschaften (z. B. die Einstellung und der Zustand der Luftdurchlässigkeit) der Anlagen erhalten bleiben. Dies gewährleistet den sicheren Betrieb der Anlage während der gesamten Betriebszeit.
Erhalten Sie jetzt eine auf Ihren OP zugeschnittene Beratung
Die Entscheidung über das raumlufttechnische Konzept für Ihre Operationsräume basiert auf dem aktuellen Stand des Wissens sowie Ihren aktuellen und zukünftigen Bedürfnissen und Anforderungen Ihrer Nutzergruppen.
Dabei werden insbesondere folgende Aspekte berücksichtigt:
- Ihre OP-Abteilungen werden für eine Nutzungsdauer von mindestens 20 bis 30 Jahren ausgelegt.
- Die steigenden Anforderungen an die Keimarmut bedingt durch demografische Entwicklungen, die Zunahme immunsupprimierter Patienten und die Häufung risikobehafteter Eingriffe.
- Die konsequente Aufgabenverteilung und anlagentechnische Umsetzung für Heiz-, Kühl- und Lüftungsanforderungen.
Welchen Anforderungen Sie gerecht werden müssen, lässt sich natürlich ohne genauere Angaben nicht sagen.
